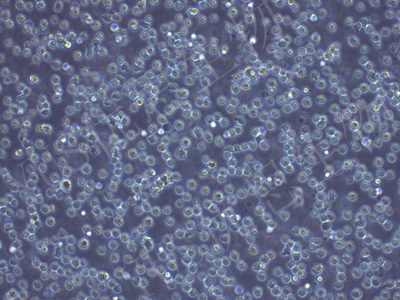

产品中心
产品中心
-

GL261 小鼠胶质细胞瘤(种属鉴定)
货号:YLM015规格: 1*10^6 -

mlMCD-3 小鼠肾髓质细胞(种属鉴定)
货号:YLM016规格: 1*10^6 -

K7M2wt 小鼠骨肉瘤成骨细胞(种属鉴定)
货号:YLM017规格: 1*10^6 -

MC38 小鼠结肠癌细胞(STR鉴定)
货号:YLM018规格: 1*10^6 -
NFS-60 小鼠髓性白血病淋巴细胞(STR鉴定)
货号:YLM019规格: 1*10^6 -

ID8 小鼠卵巢上皮癌细胞(种属鉴定)
货号:YLM020规格: 1*10^6 -

MC3T3-E1 Subclone24 小鼠成骨细胞前体细胞亚克隆24(STR鉴定)
货号:YLM021规格: 1*10^6 -

Sp2/O 小鼠骨髓瘤细胞(种属鉴定)
货号:YLM022规格: 1*10^6 -

SCC-7 小鼠鳞状癌细胞(种属鉴定)
货号:YLM023规格: 1*10^6 -

CT26 小鼠结肠癌细胞(STR鉴定)
货号:YLM024规格: 1*10^6 -

BA/F3 小鼠原B细胞株(STR鉴定)
货号:YLM025规格: 1*10^6 -

MOVAS 小鼠主动脉血管平滑肌细胞(种属鉴定)
货号:YLM026规格: 1*10^6
在线咨询
Online consultation

关注微信公众号


